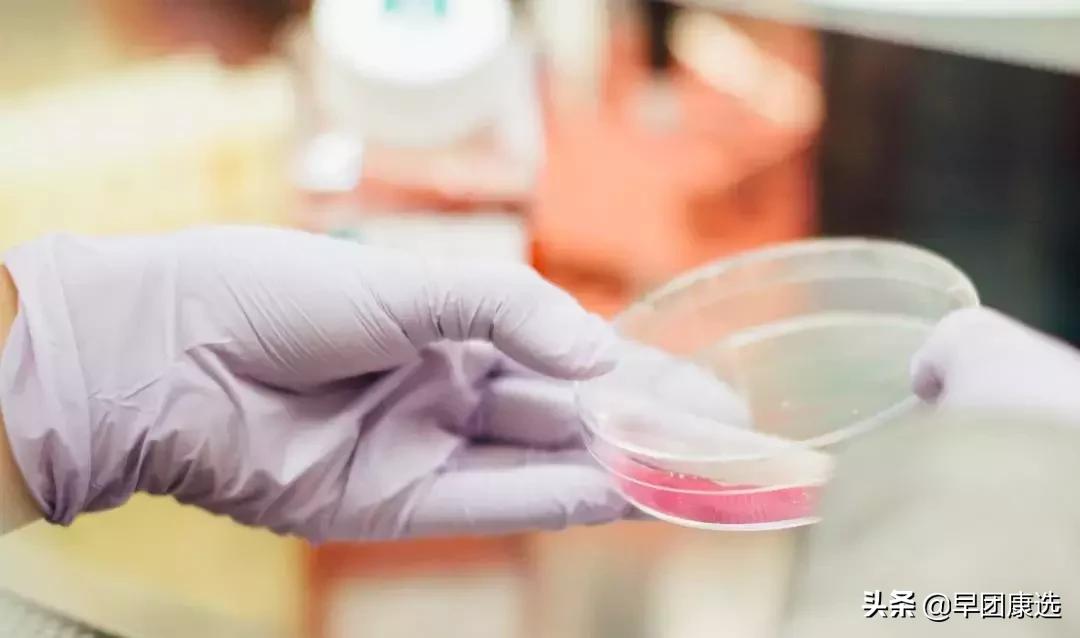
体检查出早期癌是不幸中的万幸么,年年体检为何一查出癌就是晚期

国家癌症中心发布的中国最新癌症数据《2017中国肿瘤登记年报》显示:
在我国平均每天约1万人、 每分钟约7人确诊患癌。如果一个人活到85岁,那么他的患癌风险就有36%。

更可怕的是很多人就算年年体检,年年正常,却还是突然查出癌症晚期!
年年体检,为什么还是癌症晚期?
有些人会疑惑,大大小小的体检项目做了这么多,怎么就不能防癌了?
那是因为这些体检主要检查的都是些常见病,比如高血脂、高血压之类的,压根没法对肿瘤疾病进行检测。
比如死亡率最高的肺癌,现在很多地方还在用X光片检查。虽然价格便宜,但是检出早期肺癌的概率只有0~15%!

查癌正确姿势,千万记住
肺癌少不了CT
CT扫描是用X线束对人体进行一层层的分解扫描,能无比清楚看到肺部的结构,即使小肿瘤,都能被发现。

建议筛查的高危人群:年龄40岁以上且包含以下一项危险因素。
(1)吸烟≥20包/年,包括戒烟时间不足15年的;(2)被动吸烟者;(3)有职业暴露史(石棉、铍等接触者);(4)有恶性肿瘤病史或肺癌家族史。
乳腺癌少不了乳腺钼靶
乳腺癌筛查首选的是钼靶X线。它能够观察到小于0.1毫米的微小钙化点及钙化簇。

建议筛查的高危人群:伴有以下多条高危因素时。
(1)未育或≥35岁初产妇;(2)月经初潮≤12岁,或行经≥42年的妇女;(3)一级亲属在50岁前患乳腺癌者;(4)两个以上一级或二级亲属在50岁以后患乳腺癌或卵巢癌者;(5)对侧乳腺癌史或经乳腺活检证实为重度非典型增生或乳管内乳头状瘤病者;(6)胸部放射治疗史≥10年
宫颈癌少不了TCT
强调一点,其实宫颈癌疫苗预防不是百分百的,而且只对没有感染高危病毒的人有用。所以检查还是很必要的。
TCT对癌细胞的检出率高达90%以上,还能发现癌前病变,微生物感染如霉菌、滴虫等。

建议筛查的高危对象:已婚或*生活性**史3年的女性。
食管癌少不了内镜
筛查食管癌可以先做普通的内镜检查,肉眼观察食管粘膜的改变,然后再结合染色或放大等精查的方式,来进一步的评估。

建议筛查的高危人群:年龄40岁以上且包含以下一项危险因素。
(1)来自食管癌高发区,河北河南等地;(2)有上消化道症状;(3)有食管癌家族史(4)患有食管癌前疾病或癌前病变者;(5)具有食管癌的其它高危因素,如吸烟、重度饮酒、头颈部或呼吸道鳞癌等。
胃癌少不了胃镜
生活中有胃病的不在少数,大多都不当回事。殊不知,胃痛胃胀等都是胃癌的警告!
预防胃癌,最重要的就是做胃镜检查。胃镜检查和食管癌的内镜检查相似,借助一条纤细、柔软的管子伸入胃中,直接观察胃部的病变状况,直观清晰。

建议筛查的高危人群:年龄40岁以上且包含以下一项危险因素。
(1)胃癌高发地区人群,中国西北地区及东南沿海地区;(2)幽门螺杆菌感染者(3)胃癌患者一级亲属;(4)以前患有慢性萎缩性胃炎、胃溃疡、胃息肉等胃癌前疾病(5)其他高危因素,如重度饮酒吸烟者。
结直肠癌少不了肠镜
肠镜检查可以清楚的观察到整个肠道,而且如果发现息肉,可以直接切除。

建议筛查的高危人群:50~75岁且包含以下一项危险因素。
(1)大便潜血阳性,需进行2次检测,中间相隔1周,任意一次检查阳性即为高危;(2)一级亲属有结直肠癌病史者;(3)本人有癌症或肠道腺瘤史者;(4)患有炎性肠道疾病,比如说溃疡性肠炎。
肝癌少不了甲胎蛋白+B超
单独用甲胎蛋白筛查的话会使约1/3的肝癌患者漏诊,B超刚好可以清楚的看清肝脏上的病变,两个一起检查会更准确。

建议筛查的高危人群:年龄男性35岁以上、女性45岁以上的以下人群:
(1)有乙型肝炎病毒(HBV)或丙型肝炎病毒(HCV)感染的血清学证据;(2)肝癌家族史;(3)血吸虫、酒精性肝硬化等任何原因引起的肝硬化患者;(4)药物性肝损患者。
欢迎转载,如需转载,请注明出处